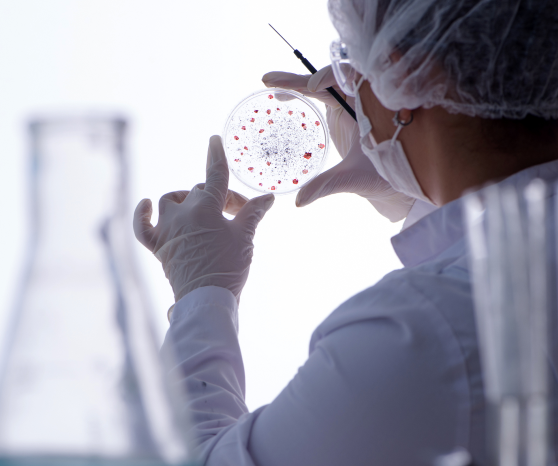

We're raising the bar on women's health
Our mission is in our name. We’re here to give you the BEST supplements out there. Ones that are clean, simple, functional, and make achieving your best health—a no brainer. That’s because we let science do the brain stuff, so you can enjoy safe, effective products that actually work.
When it comes to your BEST health, we don’t mess around. And neither should you.

Simply BEST.
Because better is just not good enough
- BEST supplements are formulated with the most effective, science-backed ingredients out there, and nothing else.
- No fillers, no false promises, and no B.S.
- Just the right doses, delivered the right way, with results that actually matter.
Our Values
Bold Integrity
We believe that our BEST health starts with the BEST standards. We always strive to deliver the best ingredients and the best, most effective products so you can have a greater peace of mind when it comes to your health.

Empowerment
We want to foster a greater sense of control over our bodies and our health. Because health is personal, and you should make the best decision for you — not somebody else.

Science First
When it comes to health, we don’t follow trends, we follow science. Making sure every ingredient we source is safe and scientifically proven, and every product we develop follows the best standard available that mirrors the pharmaceutical industry’s.

Transparency
We want you to know exactly what’s in our products (and what isn’t). We are always open and honest with our formulations and clearly communicate the list of harmful "BAD 15" ingredients we never use in any of our products.

Founded by one woman, for ALL women
Like many women going through perimenopause, I struggled to find clean, trustworthy supplements that were not only safe but also truly effective while navigating the confusing and often overwhelming symptoms.
I spent countless hours researching, reading labels, and trying various products, but I kept running into the same issues: supplements that were filled with unnecessary additives, vague ingredient lists, countless pills or ones that simply didn’t work. I knew there had to be a better way — a way to empower women like me to take control of their health and well-being with products they could actually trust.
That’s why I founded BEST Supplements. To support women through every stage of life.
We’re committed to using only the highest quality ingredients, backed by science and sourced responsibly. Our formulas are clean, effective, and designed to help women feel their best — because every woman deserves to live her BEST life, no matter what stage she's in.
Lidia Shong
CEO & Founder
Find your BEST
-
Shop Now
Vaginal Probiotic
Vaginal health/pH Balance/Relief for BV and UTIs
Probiotics + Prebiotics + Cranberry extract




